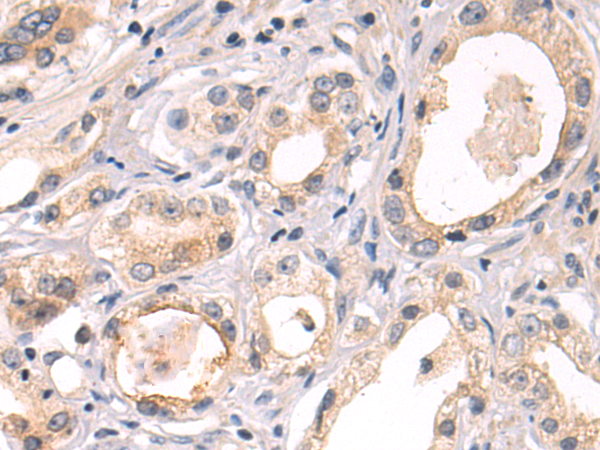
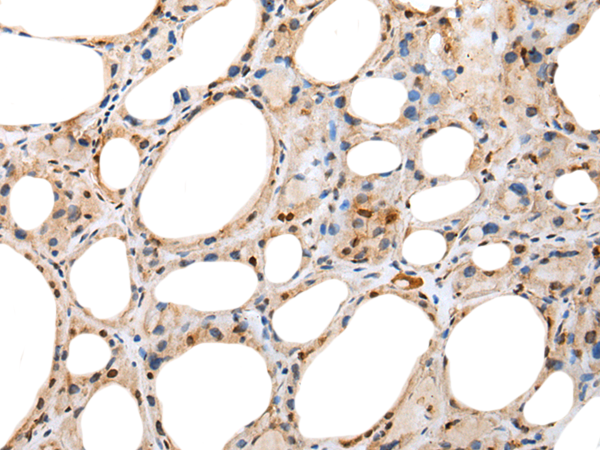
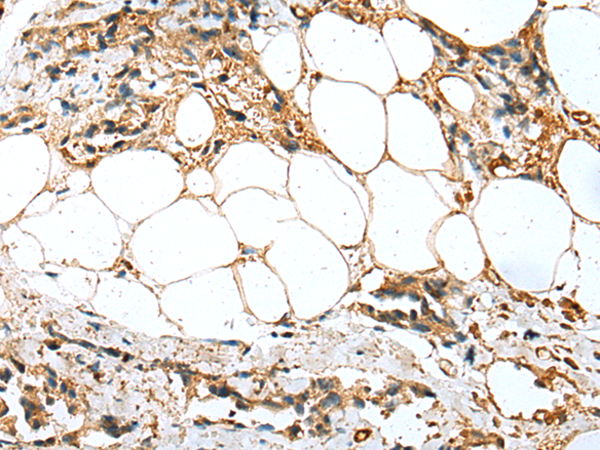

-
分类: 科研抗体货号: P02232别名:应用: WB,IHC反应种属: Human
-
分类: 科研抗体货号: P02189别名: YL8应用: WB,IHC反应种属: Human, Mouse, Rat
-
分类: 科研抗体货号: P02222别名: DCI应用: WB,IHC反应种属: Human
-
分类: 科研抗体货号: P02231别名: HEL-S-108应用: WB,IHC反应种属: Human, Mouse, Rat
-
分类: 科研抗体货号: P02187别名: MATS2; MOB4A; MOBKL1A应用: IHC反应种属: Human, Mouse
-
分类: 科研抗体货号: P02220别名: ABH8; TRM9; TRMT9应用: WB,IHC反应种属: Human
-
分类: 科研抗体货号: P02230别名: YWHAS应用: IHC反应种属: Human, Mouse
-
分类: 科研抗体货号: P02186别名: WEX7; NPD017应用: WB反应种属: Human
-
分类: 科研抗体货号: P02214别名: PRO7434; ALKN2972应用: WB,IHC反应种属: Human
-
分类: 科研抗体货号: P02229别名: NSE2; MMS21; ZMIZ7; C8orf36应用: WB,IHC反应种属: Human, Mouse, Rat

鄂公网安备42018502007531号
鄂公网安备42018502007531号

